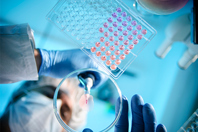

ABOUT MILTENYI BIOTEC
Miltenyi Biotec is a global provider of products and services that empower biomedical discovery and advance cellular therapy. Our innovative tools support research at every level, from basic research to translational research to clinical application. This integrated portfolio enables scientists and clinicians to obtain, analyze, and utilize the cell. Our technologies offer solutions for cellular research, cell therapy, and cell manufacturing. Our more than 30 years of expertise spans research areas including immunology, stem cell biology, neuroscience, cancer, hematology, and graft engineering. In our commitment to the scientific community, we also offer comprehensive scientific support, consultation, and expert training. Today, Miltenyi Biotec has more than 4,500 employees in 28 countries – all dedicated to helping researchers and clinicians around the world make a greater impact on science and health.
FEATURED CONTENT
-
Achieve scalable T cell manufacturing with automation, standardized workflows, and integrated quality control to enable high-yield production, flexible scheduling, and seamless tech transfer.
-
Early analytical alignment and standardized assay design reduce variability. Discover an ATP-driven approach that enables reproducible data, smoother tech transfer, and stronger regulatory readiness.
-
Precise detection of CAR T cells supports reliable analysis and imaging across workflows. See how flexible reagent strategies reduce background, improve specificity, and enable deeper insight.
-
Reliable IFN‑γ measurement is critical for understanding T cell function. See how analytical rigor, from accuracy to matrix effects, supports consistent cytokine quantification across development.
-
Gain insight into how an automated, closed workflow can integrate T cell enrichment, activation, transduction, expansion, and formulation across fresh and frozen starting materials.
-
Tracking rare immune cells is no longer limited by conventional flow cytometry sensitivity. Learn how integrated pre‑enrichment strategies enable reliable detection and improved quantification.
-
A seven‑day CAR T cell manufacturing workflow shows how cryopreserved leukapheresis material can deliver high viability and strong antitumor activity, offering a more flexible path for production.
-
Discover how standardizing reagents and automating flow cytometry workflows can improve reproducibility, reduce troubleshooting, and accelerate progress in cell-based therapies.
-
Syngeneic mouse tumor models are crucial for immunotherapy research, but variability in TILs and nonspecific binding complicate analysis. Discover how blocking reagents help but make the process more labor-intensive.
-
Explore an assay kit that simplifies handling with a methylcellulose-free medium and clear flow cytometric readout, which enhances automation and high-throughput sample acquisition for versatile research.
-
In-process and quality control ensure consistent manufacturing of gene-engineered hematopoietic stem cells. Discover an engineering process that enhances production through viral transduction and integrated sampling pouches.
-
Discover how innovative in vitro assays for CAR-T cells can enhance therapeutic outcomes by providing detailed insights into their properties and behaviors throughout pre-clinical and clinical development.
-
CAR-T cell therapy shows unprecedented efficacy in targeting cancer. Explore a device that simplifies the complex manufacturing process and enables automated CAR-T cell generation to ensure quality control and phenotyping.
-
Gain insights and key recommendations from industry and regulatory experts on navigating assay validation for cell and gene therapy throughout the product development lifecycle.
-
Flow cytometry compensation is critical, for it directly impacts data accuracy and quality. Here, we share eight tips to improve compensation in multicolor flow experiments.
-
Learn the 4 physical conditions that occur during droplet sorting, which may keep your cells from being happy.
-
Here, we demonstrate the capacity of a specific bench top sorter to allow for completely aseptic sorting conditions by using the system to sort cancer antigen-specific cytotoxic T cells out of PBMCs.
-
Isolating fully functional CAR T cells requires high quality cell separation. See how we successfully and efficiently isolated CD19 CAR T cells with the MACSprep™ CD19 CAR MicroBead Kit, human.
-
Learn how the knowledge generated by a deep and thorough analysis of chemokine receptors on natural killer (NK) cells can be helpful to scientists studying certain cancers and diseases.
-
Here, we describe the multicolor flow cytometry analysis necessary to study natural killer (NK) cell phenotype and the function of isolated NK cells from whole blood.
CONTACT INFORMATION
Miltenyi Biotec
12740 Earhart Ave.
Auburn, CA 95602
UNITED STATES